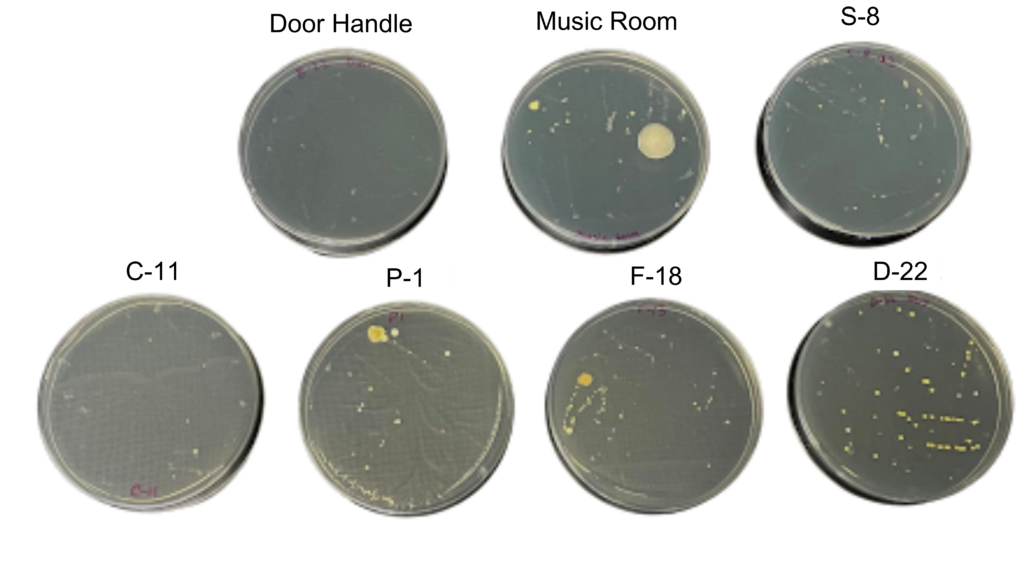

Everyone knows to wash their hands after using the bathroom, but what about the bathroom pass? “It’s sort of an impossible paradox,” Band Director William Flaherty said. “The pass itself becomes dirty, and it doesn’t matter even if students wash their hands.”
When a toilet is flushed without a lid, it releases an aerosol of bacteria into the air. Up to 145,000 microdroplets of toilet water are produced with every flush, which can carry contaminants from an infected person’s feces or vomit, according to a study from the National Institute of Health. These particles travel through the air, sticking onto nearby surfaces—including our bathroom passes.
To determine whether bathroom passes were hygienic, we collected samples from six different passes and cultivated them on petri dishes for three days, amplifying any invisible microbes present. For comparison, we also swabbed the door handle to PAWS, another commonly touched surface.
All six passes showed bacterial growth. The only dish that showed little to no growth came from the PAWS door handle—the UV from frequent sunlight may have killed most bacteria.
In order of bacterial growth, the passes were for classes: D-22, F-13, S-8, the Music room, P1, and C11. Both the D-22 and S-8 passes were from the previous quarter and were the first and third dirtiest, respectively, while the newer ones were generally cleaner.
New bathroom passes are issued every quarter, which may help limit the spread of bacteria. These results suggest that M-A’s current policy might be effective in reducing the bacteria on the passes by changing out the passes periodically.
The two dirtiest passes, from F-13 and D-22, were attached to clipboards. These clipboards are reused each quarter and were also swabbed. Their extended use and infrequent cleaning may explain the higher bacteria levels.
Although all passes showed bacteria, it is difficult to verify the type that grew on each dish. Research suggests that concern for bathroom bacteria may be unwarranted. Although bathrooms may contain trillions of microbes, not all of them are harmful, and many, especially gut bacteria, cannot survive outside of a host for long.
Still, teachers express discomfort when asked about their bathroom passes. Almost all teachers interviewed avoid handling the pass after switching it each quarter. When asked if she ever touches her pass, Biology and AP Environmental Studies teacher Erica Woll said, “Heck no. I only touch the pass at the beginning of the quarter, and that’s it.”
Students might not think twice about that plastic pass or wooden clipboard, but they’re touching a surface that dozens of others have touched too. Clean hands might not be enough if the pass itself isn’t clean, too.
